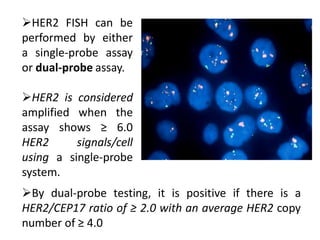
HER2 FISH can be
performed by either
a single-probe assay
or dual-probe assay.
HER2 is considered
amplified when the
assay shows ≥ 6.0
HER2 signals/cell
using a single-probe
system.
By dual-probe testing, it is positive if there is a
HER2/CEP17 ratio of ≥ 2.0 with an average HER2 copy
number of ≥ 4.0

Molecular testing techniques can be used on cytology specimens to facilitate cancer patient management. Fluorescence in situ hybridization (FISH) is well-suited for detecting genomic abnormalities in cytology specimens. FISH involves hybridizing fluorescent probes to target sequences to visualize locations. It can detect gains, losses, amplifications, and rearrangements. A variety of cytology specimens can be used for FISH, including smears, cell blocks, and liquid-based preparations. FISH has applications in detecting abnormalities in cancers like urothelial carcinoma, breast cancer, and lymphoma.